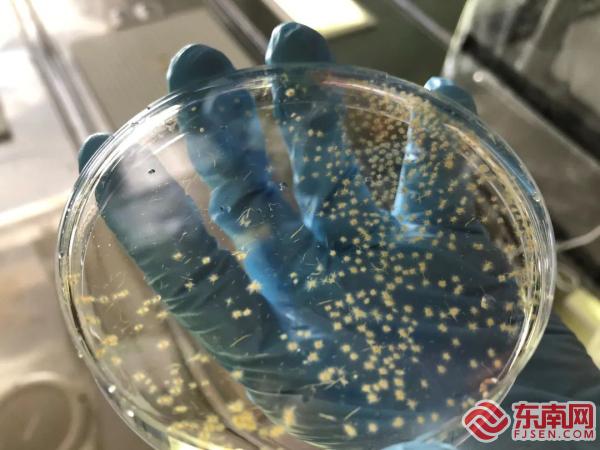

厦大“有洁癖”团队 致力破解海洋固氮生物“点石成金”之谜
| 2022-03-16 11:25:53 来源: 东南网 责任编辑: 刘学佳 我来说两句 |
分享到:
|
东南网3月16日讯(通讯员 曾文萃)你知道吗?你此刻呼吸的空气,约78%由氮气组成,可氮气的化学性质很不活泼,几乎无法被生物利用。不过,有这样一群“雷锋”,它们拥有“点石成金”的能力,能把氮气转化为生物可利用的氮营养盐,从而造福其他生物。它们的名字叫作“固氮生物”,它们固氮的过程叫作“生物固氮作用”。 在广阔的海洋里是否有固氮生物?它们在全球海洋的分布格局如何?生物固氮作用的机理是什么?受到哪些因子的调控?……如今,关于生物固氮,还有无数谜团正等待着科学家们解开。厦门大学近海海洋环境科学国家重点实验室的史大林教授课题组就是这“解谜团”中的一员。 今年2月,近海海洋环境科学国家重点实验室史大林教授课题组与国内外合作者在Science Advances发表了题为Nutrient regulation of biological nitrogen fixation across the tropical western North Pacific的研究论文,揭示了铁和氮供给比率(Fe:N supply ratio)是调控热带和亚热带西北太平洋生物固氮的重要因子,为全球海洋尺度上认识海洋生物固氮的时空格局及其调控机理提供了重要的观测和理论依据。 去海上解谜
固氮生物——束毛藻(受访者供图) 论文第一作者,厦门大学博士后温作柱介绍道:“开阔的大洋就像一片贫瘠的土壤,营养物质极度匮乏,生活在大洋里的浮游植物一直都是‘饿着肚子’的。” 在海洋浮游植物中,固氮生物仅占非常小的一部分,虽然少,但它很重要。因为它可以通过体内的固氮酶,将氮气转化为生物可利用的氮营养盐,从而给自己和其他浮游植物提供营养。据估算,固氮生物可贡献高达50%的海洋外源生物可利用氮。 有了固氮生物“施肥”,其他浮游植物便可获得养分执行光合作用、吸收大气中的二氧化碳,从而调节全球气候。也就是说,如“蝴蝶效应”一般,生物固氮作用最终对调节全球气候,可能具有重要作用。在全球热带、副热带海域,生物固氮作用普遍存在,但它的时空格局如何?调控因子又是什么?这些成了史大林团队致力破解的“谜题”。
史大林在“嘉庚”号上(受访者供图) “我们从2013年就开始做海洋现场观测的工作了。”史大林表示,“现场观测与实验室研究相辅相成,是我们团队的传统。”秉持着这样的研究理念,多年来,团队始终坚持去到现场开展生物固氮的研究。 为此,团队学生里的“老大哥”温作柱前后参与了十几个科考航次,共计在海上待了300多天。“我有连续三年的生日都是在海上过的,也在海上给很多人过过生日。”他笑着说。 |
相关阅读:
 |
打印 | 收藏 | 发给好友 【字号 大 中 小】 |